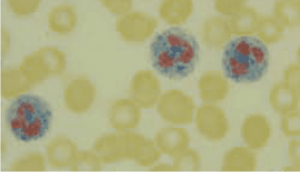

Leukocyte Alkaline Phosphatase (LAP) Test: LAP Score in Leukemia Diagnosis
LAP test
Synonyms
LAP, LAP Score, LAP Smear
Abstract
A cytochemical test that helps differentiate **chronic myeloid leukemia (CML)** from **leukemoid reactions**, especially in the diagnosis of **myeloproliferative disorders**.
Specimen
Whole blood (via fingerstick)
Container
Long glass slides with blood smears
Collection Instructions
- Smear blood from a fingerstick onto **six long slides**.
- Allow slides to **air dry immediately**.
- Transport to hematology within **30 minutes**, ideally.
Storage Instructions
- Fix slides within **8 hours** (preferably within 30 minutes) using:
- Cold 10% formalin methanol, or
- Citrated buffered acetone
- After fixation, smears may be stored for **up to 8 weeks** before staining.
Reason to Reject Sample
- EDTA-anticoagulated blood used
- Transport delay beyond 30 minutes
- Neutrophil count < 1000/mm³
Reference Range
Normal LAP Score: 11–95
Use
- Differentiating **chronic granulocytic leukemia (CML)** from **leukemoid reaction**
- Evaluating **polycythemia vera**, **myelofibrosis**, and **Hodgkin’s disease**
Limitations
- **Elevated LAP** seen in pregnancy, infections, postoperative states, and Hodgkin’s disease.
- Test requires a sufficient number of **mature neutrophils** in peripheral blood.
- **Low LAP scores** do not vary with total WBC count in CML.
Methodology
The LAP enzyme reacts with **naphthol substrates** and **diazonium dyes** (e.g., fast blue RR), producing a **colored precipitate**. Based on staining intensity, neutrophils are scored from **0 to 4+**. The **LAP score** is the sum of the scores for **100 neutrophils**.
Additional Information
- Low LAP scores are seen in:
- Chronic myeloid leukemia (CML)
- Paroxysmal nocturnal hemoglobinuria (PNH)
- Hereditary hypophosphatasia
- Thrombocytopenic purpura
- High LAP scores observed in:
- Polycythemia vera
- Myelofibrosis
- Hairy cell leukemia
- Leukemoid reaction
- Hodgkin’s lymphoma
- LAP does **not increase** during **sickle cell crisis**, possibly due to hypothalamic-pituitary-adrenal axis dysfunction.
- **Northern blotting** shows absent LAP mRNA expression in CML, indicating no or defective gene transcription.
References
- Jacobs, Demott, Finley, Horvat, Kasten.JR, & Tilzer. “Laboratory Test Handbook.” Lexi-Comp Inc, 1994.
- Catovsky D. “Leukocyte Cytochemical and Immunological Techniques.” Practical Haematology, 7th ed, 1991.
- Cline MJ. “Benign Quantitative Granulocyte and Monocyte Disorders.” Hematology: Clinical and Laboratory Practice, Vol 2, 1993.
- Kaplow LS. “Cytochemistry of Leukocyte Alkaline Phosphatase.” Am J Clin Pathol, 1963; 39:439–49.


